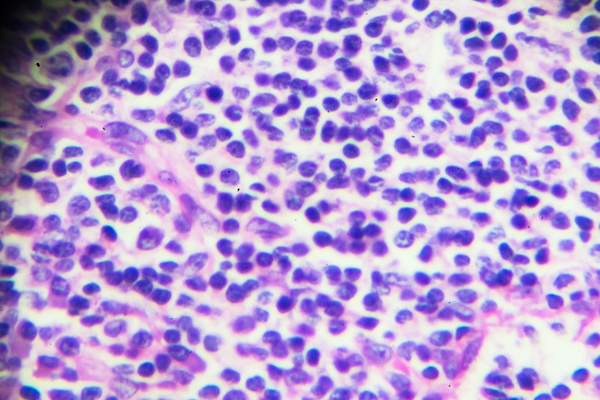
在显微镜下嗜酸性粒细胞的血细胞。

解码你的银屑病关节炎Bloodwork


你的风湿病专家已经排除了其他疾病一连串的,它的最终解决:你有银屑病关节炎。但是,当你认为你的妙语连珠的对答与抽血已经走到了尽头,没有那么快:除了常规的X光片,医生会监测你的银屑病关节炎疾病活动 - 主要是:炎症在其不同的形式存在,这导致皮损,加入疼痛,关节损伤- 每三个月到一年一次,这取决于你的预后bloodwork。请继续阅读以了解更多信息。

CBC使用自动微分
一个标准的血液测试,全血细胞计数(CBC)具有自动差将是完全医嘱什么。你可能熟悉CBC;最初级保健医生对其进行管理后,物理检查您的整体健康。自动差动监测炎症和免疫系统的细胞在你的血液测试嗜中性粒细胞,淋巴细胞,单核细胞,嗜酸性粒细胞和嗜碱性粒细胞的百分比。(参见后述)。

血沉
你的医生会使用ESR,又名sed的速度,验血来监控您的慢性炎症水平。测试捕捉你的红血细胞是如何快速沉降在管底部;标准范围为这个测试是每小时毫米零和20之间。桑达率测试还可以帮助医生确定如何您的治疗过程 - 从非甾体类消炎药如布洛芬来缓解疾病的药物如生物制剂 - 工作。

C反应蛋白
的C-反应蛋白测试还施用到监视器炎症水平,但是它倾向于捕获急性炎症。的标准范围是零毫克每升血液C-反应蛋白的至10mg / L之间。

白色和红细胞计数
高白细胞计数也可能表明炎症。低红细胞计数指示贫血,一个共同的银屑病关节炎合并症。你的风湿病还可以检查验血独立于CBC一个你总铁水平。贫血银屑病关节炎是抓尤其重要,因为大多数患者已经有疲劳的一些水平由于细胞因子的存在,蛋白质在炎症反应释放。

淋巴细胞
淋巴细胞(也称为T细胞和B细胞)是白血细胞缓和机体的免疫应答。T细胞是负责释放细胞因子,在许多银屑病关节炎患者造成疲劳无贫血。甲正常淋巴细胞的范围是总的白血细胞的18-45%的之间,以及低淋巴细胞计数可以指向自身免疫病症或免疫抑制药物治疗呢。

中性粒细胞
这种类型的白血细胞的响应,并打架,感染。低嗜中性粒细胞计数(小于2500每微升血液中)用信号通知过度活跃的免疫系统和指向一个感染的存在或自身免疫病症。低中性粒细胞计数(中性粒细胞)可能会出现作为用于治疗银屑病关节炎某些药物的结果,如果中性粒细胞是存在你的医生会考虑这一点。

单核细胞
也有白细胞,单核细胞帮助人体抵抗疾病和修复的免疫反应之后。单核细胞的高百分比 - 10%以上 - 疾病的信号的存在。
嗜酸性粒细胞
你的风湿病还可以检查您的嗜酸性粒细胞,白细胞是打架过敏和感染相关的炎症。如果嗜酸性粒细胞建立 - 超过350绝对计数 - 超过350绝对计数,这可以反映过敏或炎症过程,你的身体正在处理。

嗜碱性粒细胞
这种白细胞的战斗侵略者如寄生虫,也预示着慢性或急性炎症。(它也负责释放组胺,过敏化合物。)甲嗜碱性粒细胞计数零和2%之间是最佳的。

底线
银屑病疾病是所有关于炎症。如果你的水平很高,说话与你的医生讨论如何通过减少您的慢性炎症处方药,饮食和生活方式的改变。全身炎症反应加重银屑病关节炎,并可能导致其他疾病,包括心脏疾病,肥胖症和抑郁症,所以最好保持你的水平和工作标签一起把火势控制住。